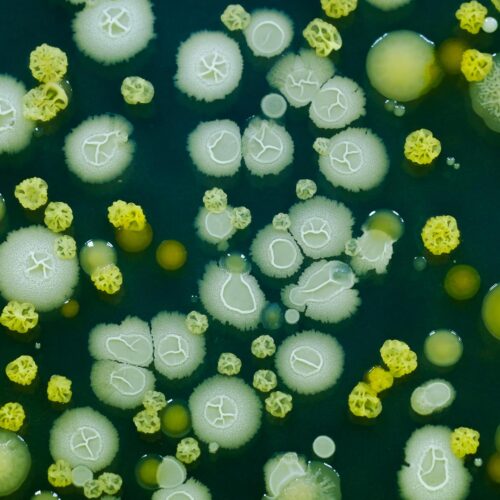

Reliable insights about your customers’ needs are vital to creating successful products.
Our human expertise and user-friendly technology allow you to quickly gather customer perspectives on a global scale, test and retest product ideas with your target audience, and understand exactly what your customers expect from your product. With this level of customer understanding, you can minimize the risk of R&D investment, shorten time to market, and make informed adjustments on the fly as you deliver superior products over and over again.